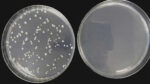
petrischalen.jpg

SafeTouch Antimikrobielle Wandschutzfolie: 99,99% Schutz gegen Keime
Hygiene neu gedacht: Die SafeTouch Wandschutzfolie ist mehr als nur ein Kratzschutz. Ausgestattet mit dem innovativen Wirkstoff Zinkpyrithion, eliminiert diese transparente Folie aktiv 99,99% der Bakterien und reduziert die Virenlast auf Oberflächen drastisch.
Ideal für Bereiche mit hohem Publikumsverkehr wie Krankenhäuser, Schulen oder Büros. Schaffen Sie ein sicheres Umfeld für Mitarbeiter und Besucher – einfach durch Aufkleben.
🔬 Warum SafeTouch besser schützt
Im Gegensatz zu herkömmlichen Beschichtungen ist der Wirkstoff hier nicht nur aufgesprüht.
- Tiefenwirkung: Das Zinkpyrithion ist fest in die Folie integriert (eingekapselt).
- Dauerhafter Schutz: Die Wirkung nutzt sich nicht ab – garantiert aktiv für 3 Jahre.
- Antiviral: Nachgewiesene Wirkung gegen das menschliche Coronavirus HCoV-229E (74,30% Reduktion).
- Antibakteriell: Reduziert Bakterienkolonien um 99,99%.
Wo ist der Einsatz unverzichtbar?
Diese Folie gehört überall dort hin, wo viele Menschen Oberflächen berühren (“High-Touch-Points”):
Empfangstheken, Türen, Bettgestelle und Wartezimmer in Arztpraxen.
Schreibtische, Lichtschalter, Handläufe und Touchscreens in Schulen oder Großraumbüros.
Haltestangen, Ticketautomaten und Glasflächen in Bussen und Bahnen.
Technische Spezifikationen
| Wirkstoff | Zinkpyrithion (integriert) |
| Stärke | 80 Mikron (0,08 mm) – Transparent matt |
| Wirksamkeit | Garantierte 3 Jahre (auch nach Reinigung) |
| Temperaturbereich | -40 °C bis +90 °C |
| Folienabmessungen | Maße: Breite: 137 cm, Länge: 25 oder 50 m Rollen verfügbar. |
Die Folie ist dermatologisch getestet und hautfreundlich (“safe to touch”). Sie ist jedoch nicht für den direkten Kontakt mit unverpackten Lebensmitteln zugelassen (kein direkter Lebensmittelkontakt nach EU-Verordnung). Ideal für Tische im Gastgewerbe, sofern Teller/Unterlagen genutzt werden.
Häufige Fragen zur SafeTouch Folie
Hilft die Folie gegen Corona-Viren?
Ja. Tests haben eine antivirale Wirkung von 74,30% gegen das menschliche Coronavirus HCoV-229E bestätigt. Sie ersetzt keine Desinfektion, reduziert aber das Übertragungsrisiko zwischen den Reinigungsintervallen signifikant.
Nutzt sich der Schutz durch Putzen ab?
Nein. Da das Zinkpyrithion fest in die Folienstruktur eingebunden ist (und nicht nur oberflächlich aufgedruckt), bleibt die antimikrobielle Wirkung auch bei täglicher Reinigung mit aggressiven Mitteln für mindestens 3 Jahre bestehen.
Kann ich die Folie auf Touchscreens kleben?
Ja, die Folie ist transparent und beeinträchtigt die Touch-Funktion nicht. Sie eignet sich hervorragend für Tablets, Check-In-Terminals oder Ticketautomaten.
Ist der Wirkstoff schädlich für die Haut?
Nein, die Folie wurde dermatologisch getestet. Sie ist hautfreundlich und löst keine Reizungen aus.
Schützen Sie Oberflächen dort, wo es zählt.
Wählen Sie jetzt Ihre Rollenlänge ⬇️
Herstellerinformationen GPSR
Add Connect UG (haftungsbeschränkt) & Co. KG
Gütersloher Str. 69 a – 33161 Hövelhof
Telefon: (+49) 05257 934403
www.add-connect.de